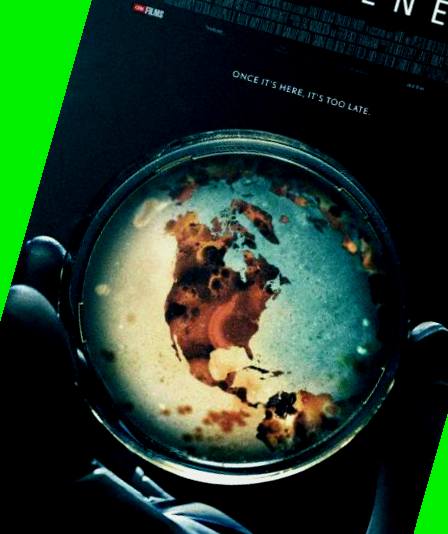

正在觀看《成人午夜高潮免费视频在线观看,av永久免费》全集